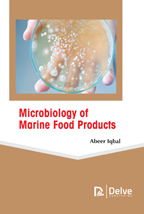

Tab Article
All food products possess their own characteristic microbiology. Nevertheless, out of all the fodder commodities, seafood is considered to have the most complex and diverse microbiology. In contrast to poultry or meat products where a few living species are categorized in each group, the term seafood covers hundreds of species and genera. This book offers a comprehensive investigation of microbiological safety and quality concerns of seafood. The detailed analysis of seafood products in different stages is presented in the book including harvest stage, processing stage and consumption stage. Most of the chapters in the book are comprehensively written based on latest data. An intensive effort has been made to integrate discussions on matters that are both timeless and timely. There are eight chapters in the book in which some of the topics are not essentially "microbiological' in nature; however, these topic are key to any meaningful information on seafood safety; these may include: Parasites, Thermal Processing, Deªpuration, and Natural Toxins. This book interprets seafood microbiology and seafood industry from the standpoints of processing influences and environªmental influences. It will serve as an impetus for prospective research in these two areas of food industry, and bring the paradigms of safety and quality into effect.